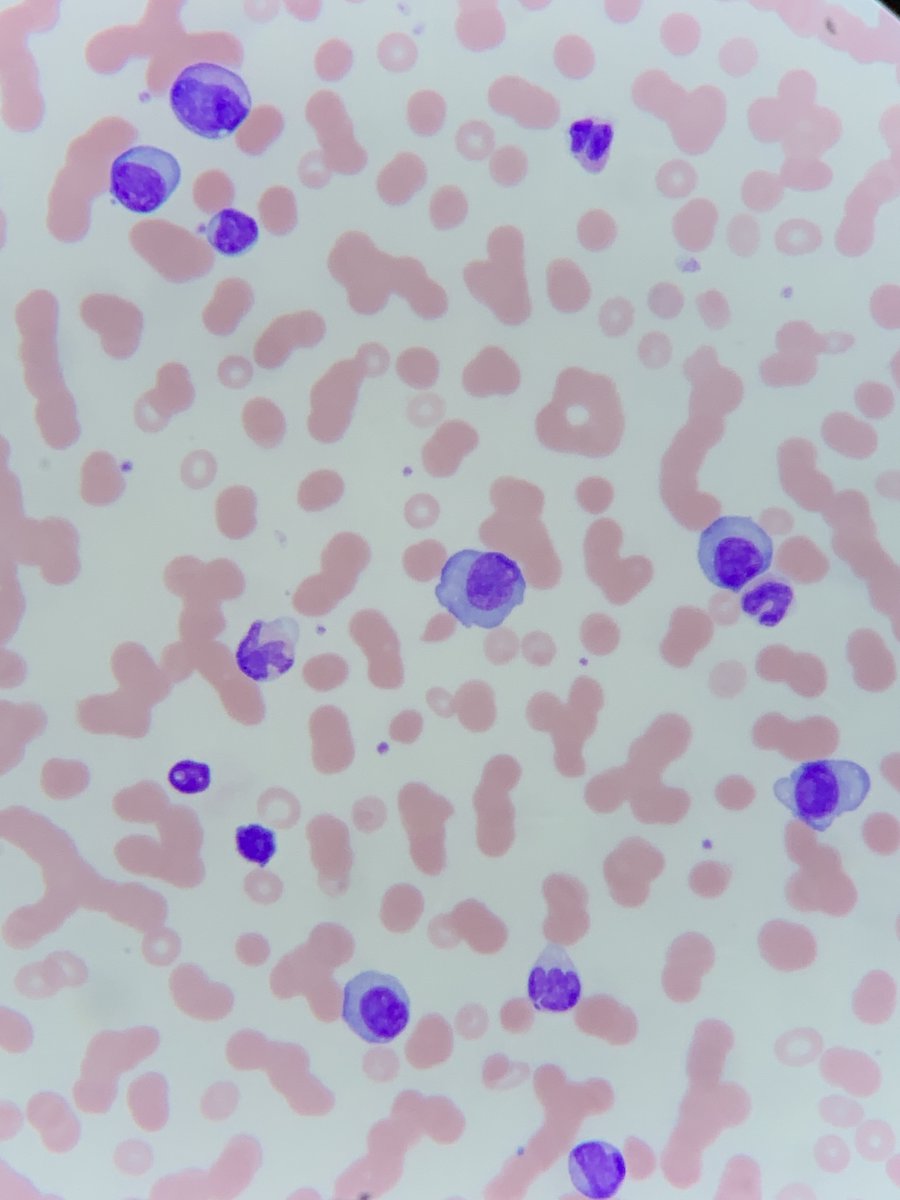
1. One of the questions I get asked a lot is "how do you take such decent microscope photos on your phone?"How do you go from the image on the left to one on the right? Quite simple really... ready for a short thread?
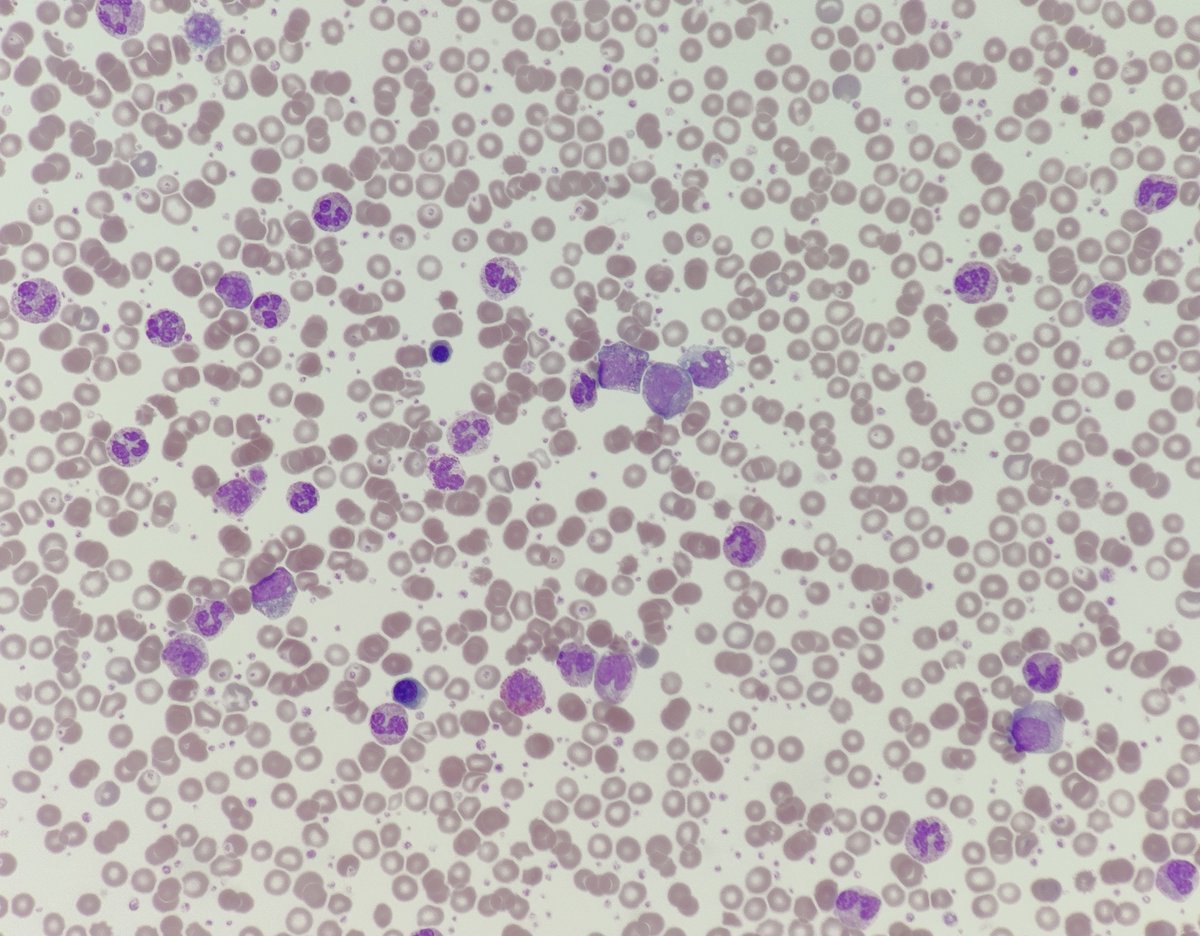
6. Happy taking amazing photos  #underthescope. All those below are taken without a mount. Do you have any images you've taken that you'd like to share? Feel free to do so in the replies!

1. One of the questions I get asked a lot is "how do you take such decent microscope photos on your phone?"
How do you go from the image on the left to one on the right?
Quite simple really... ready for a short thread?
How do you go from the image on the left to one on the right?
Quite simple really... ready for a short thread?
2. Firstly, it is useful to have a mount that allows you to connect your phone to the microscope.
Don't worry if you don't have one. I usually do it by holding my breath, resting my elbows on the arms of a chair or the table for stability.
Don't worry if you don't have one. I usually do it by holding my breath, resting my elbows on the arms of a chair or the table for stability.
3. If you're not using a mount, then start away from the microscope and slowly move towards it. Follow the light. I use some of my 'free' fingers to rest against the microscope and provide better stability.
4. If you're using a mount...
Find how to lock your phone's auto-focus, then follow the steps. You can do this both on an Android or iPhone. Most phone cameras these days have excellent zoom lenses. So it increases photo quality if you use that rather than cropping afterwards.
Find how to lock your phone's auto-focus, then follow the steps. You can do this both on an Android or iPhone. Most phone cameras these days have excellent zoom lenses. So it increases photo quality if you use that rather than cropping afterwards.
5. If you don't have a mount...
Pre-zoom using your phone camera's viewfinder so when you move towards the objective the image fills the screen. You'll need to play around a little to see which zoom works best for your phone.
Steady hands and perseverance are most important!
Pre-zoom using your phone camera's viewfinder so when you move towards the objective the image fills the screen. You'll need to play around a little to see which zoom works best for your phone.
Steady hands and perseverance are most important!
6. Happy taking amazing photos #underthescope. All those below are taken without a mount.
Do you have any images you've taken that you'd like to share? Feel free to do so in the replies!
Do you have any images you've taken that you'd like to share? Feel free to do so in the replies!

 Read on Twitter
Read on Twitter